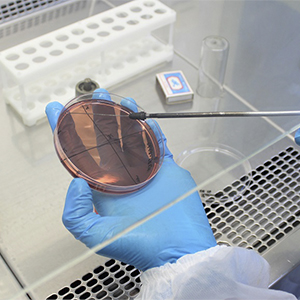

Пружанская районная ветеринарная станция Учреждение
Ветеринарные услуги, консультация. Лечение, профилактика, вакцинация, лабораторные исследования, ветеринарно-санитарный надзор.
Ветеринарные услуги, уход за животными
Ветеринарные услуги, консультация. Лечение, профилактика, вакцинация, лабораторные исследования, ветеринарно-санитарный надзор.

Хирургия

Стоматология

Онкология

Травматология

Терапия

Офтальмология

Дерматология

Диагностика

Вакцинация животных

Ветеринарная аптека

Ветеринарная помощь мелким животным

Ветеринарная помощь крупным животным
Ветеринарные лабораторные исследования

Вызов ветврача на дом

Прием и консультации ветеринара

Хирургические, терапевтические манипуляции с животными

Вакцинация животных, птиц

Продажа ветеринарных препаратов

Выдача паспорта на животного

Оказание ветеринарных услуг

Ветеринария

Выдача ветеринарных сопроводительных документов

Ветеринарные анализы

Лечебно-профилактические услуги для домашних животных
Контактная информация
- +375 (1632) 2 96 xx (Приемная)
- +375 (1632) 4 47 xx (Главный бухгалтер, юрист)
-
Пн
 08:00 - 17:00
08:00 - 17:00 13:00 - 14:00
13:00 - 14:00 -
Вт
 08:00 - 17:00
08:00 - 17:00 13:00 - 14:00
13:00 - 14:00 -
Ср
 08:00 - 17:00
08:00 - 17:00 13:00 - 14:00
13:00 - 14:00 -
Чт
 08:00 - 17:00
08:00 - 17:00 13:00 - 14:00
13:00 - 14:00 -
Пт
 08:00 - 17:00
08:00 - 17:00 13:00 - 14:00
13:00 - 14:00 -
СбВыходной
-
ВсВыходной
-
Реквизиты:
Учреждение «Пружанская районная ветеринарная станция»
225133, г. Пружаны, ул. Григория Ширмы, 79
IBAN: BY84BAPB 3632 2709 0002 1000 0000
IBAN: BY61BAPB 3604 2709 0001 1000 0000 (бюдж.)
Банк: Филиал ОАО «Белагропромбанк» Брестское областное управление 225133, г.Пружаны, ул.Урбановича, 3
BIC: BAPBBY2X;
УНП: 200027282;
ОКПО: 007468571000
E-mail: rvs@pruzhanyvet.brest.by
GLN номер: 4819385070005 (сертификат от 15.05.2023)
Провайдер: ООО «Бидмартс»Начальник Валюшко Екатерина Васильевна действует на основании Устава
Заместитель начальника Каретко Татьяна Сергеевна действует на основании Устава

Контактное лицо

- Валюшко Екатерина Васильевна
- Начальник



